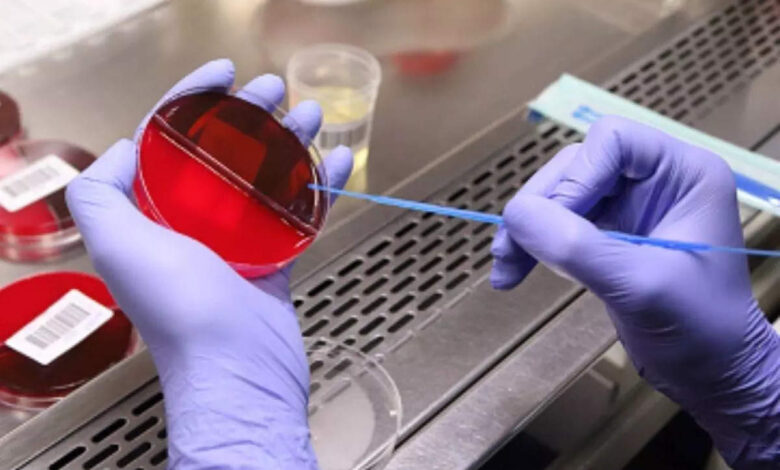

9. कैंसर का निदान अब होगा आसान, बस एक ब्लड टेस्ट से 50 तरह के Cancer की होगी पहचान
कैंसर का नाम सुनते ही लोगों के पैरों तले जमीन खिसक जाती है. लेकिन सच्चाई यह है कि हर साल दुनिया में कैंसर के कारण लगभग 96 लाख लोगों की मौत हो जाती है. डब्ल्यूएचओ के मुताबिक विश्व में बीमारियों के कारण होने वाली मौतों में कैंसर दूसरी सबसे बड़ी वजह है. भारत में भी कैंसर के मामले तेजी से बढ़ते जा रहे हैं. हर साल देश में 19 से 20 लाख कैंसर के नए मामले सामने आ रहे हैं. कैंसर से मौत इसलिए ज्यादा होती है क्योंकि इसका पता शुरुआती दौर में नहीं चल पाता है. अगर शुरुआती दौर में कैंसर का पता चल जाए तो अधिकांश मामलों में मरीज मौत से बच जाएंगे. इस मामले में एक अच्छी खबर सामने आई है. वैज्ञानिकों ने एक ही ब्लड टेस्ट से 50 तरह के कैंसर की पहचान करने का दावा किया है. कैंसर के समय रहते निदान की दिशा में इस खोज को बड़ी कामयाबी के तौर पर देखा जा रहा है. शुरुआती चरणों में इसके बेहतर परिणाम भी देखे गए हैं.
यह खोज बड़ी कामयाबी
अगर समय रहते लोगों में कैंसर की पहचान और समस्या का सही निदान और इलाज हो जाए तो रोगी की जान बचाई जा सकती है. इससे कैंसर के कारण होने वाली मृत्युदर को अब कम किया जा सकता है. शोधकर्ताओं ने एक ऐसे ब्लड टेस्ट के बारे में बताया है जिसकी मदद से 50 तरह के कैंसर का निदान किया जा सकेगा. कैंसर के समय रहते निदान की दिशा में इस खोज को बड़ी कामयाबी के तौर पर देखा जा रहा है शुरुआती चरणों में इसके बेहतर परिणाम भी देखे गए हैं. जब कैंसर के इलाज की बात होती है तो सबसे जरूरी होता है कि सही वक्त पर कैंसर का डिटेक्शन हो जाना और कैंसर का सही वक्त पर पता चल जाना.
पांच हजार लोगों पर अध्ययन
अक्सर कैंसर के बारे में मरीज को थर्ड या फोर्थ स्टेज में पता लगता है और तब तक कैंसर से बचना भी मुश्किल हो जाता है. गैलरी टेस्ट एक ऐसी ब्लड टेस्ट है जिसमें जो रिपोर्ट आती है उसमें पता चल जाता है कि बॉडी के किस पार्ट में या ऑर्गन में यह दिक्कत है या कैंसर बन रहा है. गैलेरी टेस्ट के माध्यम से रोगी के जेनेटिक कोड की बिट्स में अलग-अलग बदलावों को समझने की कोशिश की जाती है. जब यह स्टडी की गई तो 5000 लोगों में 85% ऐसे लोग मिले जिन में कैंसर के मामले सामने आए. ऐसे कई रेयर कैंसर है जिनका वक्त पर पता नहीं चल पाता. यह टेस्ट ऐसे रेयर कैंसर की रोकथाम में मदद करेगा. इससे कॉमन कैंसर को डिटेक्ट करना आसान है. भारत में नॉन कम्युनिकेबल डिजीज की संख्या लगातार बढ़ती जा रही है. कैंसर भी इसी तरह की बीमारी है जिसका ग्राफ ज्यादा बढ़ता जा रहा है अगर हमारे पास इस बीमारी का इतना इजी टेस्ट होगा तो ग्राफ नीचे आएगा और लोगों को आसानी होगी. भारत मैं इस टेस्ट की जल्द आने की उम्मीद है. बाहर यह टेस्ट अभी उपलब्ध है और लोग के लिए काफी अच्छा साबित हो रहा है. भारत में कैंसर प्रिवेंशन के ऊपर काफी काम चल रहा है. भारत के अंदर टेस्ट की अफॉर्डेबिलिटी होना ज़रूरी है.



